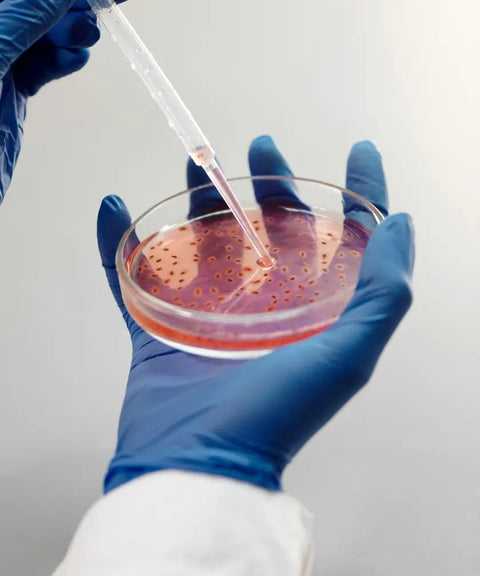

Which filter is right for you?
Answer a few questions so we can contact you with our recommendations.
About International Filter Products
Our extensive experience in advanced filtration technology spans over two decades. We specialize in bio-pharmaceutical, sterile compounding, health & wellness, chemical, and food & beverage industries.
FAQ
PES membranes are hydrophilic, making them suitable for filtering aqueous-based solutions, while PTFE membranes are hydrophobic, ideal for oil or alcohol-based solutions. We highly recommend checking the chemical compatibility prior to filtration.
Our Dual Layer membranes are state-of-the-art, featuring a highly asymmetric design with a built-in pre-filter that enhances the filtration volume by 20%-40% by protecting the final media. A dual layer filter will cost only 15% extra, ensuring cost efficiency and enhanced performance. These advanced membranes offer superior bioburden reduction and filtration quality.
Yes. All the filter products offered by International Filter Products are validated for safe human and veterinary use.
Yes. Our filters are manufactured without the intentional addition or use of any animal-derived materials, mitigating the risk of transmissible spongiform encephalopathies (TSE) and bovine spongiform encephalopathy (BSE).
Yes. All our Sterile Compounding Filters comply with USP <797> standards.
No, reusing filters in these critical applications is not allowed due to the high risk of contamination.
The volume filtered varies significantly depending on your solution's viscosity, particle distribution, active ingredients, and other properties. The best method is to try the filter with your specific solution. Refer to our Guide for Filtration Volumes for appropriate volume ranges.
Sterilizing-grade membrane filters are validated for their ability to sterilize fluids, typically challenged with the test microorganism Brevundimonas diminuta at a level of 10^7 per cm^2, in accordance with ASTM F838-15. The sterilizing grade is also referred to as pharmaceutical-grade membrane, and absolute micron rating membranes of 0.2um or less qualifies for this category.
Yes. Our flagship products, PureFlo 0.2um or lower micron rating PES or PTFE membranes, have full validation as sterilizing grade or pharmaceutical grade membranes.
Yes, we stock factory-sterilized or ETO-sterilized filters. We can also provide Gamma Irradiation Stable and autoclavable non-factory sterilized filters.
With ample inventory in stock, most items in our catalog are eligible for 1-3 day shipment. Out-of-stock items can be shipped within 2-14 weeks.
Yes. Our engineering team, consisting of professionals with a rich diversity of backgrounds and significant industry experience, provides unparalleled expertise in filtration. We are pleased to offer our customers complimentary technical advice, leveraging our team's comprehensive knowledge, extensive customer network, and robust manufacturer support.
Still have questions?
We're here to help. You can reach out to us so we can help answer any questions you have.